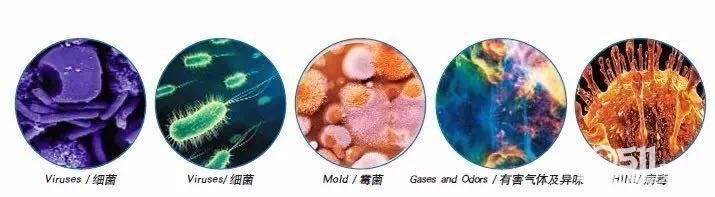

企业介绍
“净卫士”是福州比美特环保产品有限公司旗下品牌之一,公司成立于2008年,位于拥有2200年历史文化的古城并被誉为“有福之州”福州,企业所在仓山浦上工业园内的厂区占地面积5000多平米、办公区3000多平米。公司是集化工产品、水性涂料等新型材料的研发、生产、市场推广以及设计装潢服务于一体的综合型企业。
多年来,企业联合全国多所著名高等院校,立足科技创新,建立了长期、稳定的紧密关系,共同研发的几十项创新技术并获得了国家发明专利。企业全面引进国内外先进的全自动真空生产设备、技术和人才。企业全面通过ISO9001:2008国际质量管理认证。从而打造了绿色环保、健康品质、专业服务和品牌实力等综合优势。2013年正式被省科学技术厅授予2013年首批科技型企业。
品牌历史
2008 起源 福州比美特环保产品有限公司于2008年涉及液体壁纸新型水性涂料领域,是中国最早自主设计研发、生产和销售液体壁纸的专业型大型企业之一。
2010 实力 比美特与福建省著名学府“闽江学院”多位博士、导师、专家紧密合作共同研发出具有国际先进水平的除醛技术。
2010 创立 净卫士品牌设立并申请国家商标。
2011 研发 净化水项目研发成功并追加研发经费。
2012 发展 企业与闽江学院签订战略合作协定,设立教学基地。
2012 创新 抗冻产品研发成功并投入生产。
2012 战略 硅藻泥项目投入试运行。
2013 进取 企业与软件学院签订互设实训基地合作。
2013 运筹 举办“硅藻泥除醛技术研讨会”,企业合作的著名高校领导和研究人员骨干参加了会议研讨。
2013 帷幄 企业和闽江学院共同承担的“硅藻泥除醛技术”项目通过成果鉴定,达到国际先进水平。企业在高校设立联合办学点,主要针对硅藻泥的施工工艺技术进行研究、设计、教学。
2013 价值 企业被福建科技厅授予“福建省科技型企业”称呼。
2014 加强 净卫士硅藻泥渠道部门线下指导。
2015 价值 “中国科学院”及“清华大学专家博士”加盟净卫士硅藻泥研发团队。
2016 净卫士硅藻泥在上海挂牌上市。
关于净卫士
【此处为站外链接,请谨慎打开】 【此处为站外链接,请谨慎打开】
工艺介绍
【此处为站外链接,请谨慎打开】 【此处为站外链接,请谨慎打开】 【此处为站外链接,请谨慎打开】 【此处为站外链接,请谨慎打开】 【此处为站外链接,请谨慎打开】
想更多的了解净卫士硅藻泥,可以点击我们的官网:【此处为站外链接,请谨慎打开】
也可以来我们的门店:镇江市运河路87号
或者直接联系我们:座机0511-84432618
樊樊 17768658650
盼盼 17768654089
QQ:987845920
部分网友日记及链接:(更多网友日记请看家装版)
因为老婆懒得写所以我来写的装修日记(作者:普京爸比)
http://bbs.my0511.com/f95b-t5342179z-1#pid90423780
中南复式,清新小美地中海混搭风(作者:木果果)
http://bbs.my0511.com/f95b-t5993886z-1#pid92670355
[ 本帖最后由 左岸浮华 于 16-7-30 22:02 编辑 ]
- 来自 江苏省
- 精华 0
- 注册 2011-4-14
- 行业 商业贸易
- 来自 江苏省
- 精华 0
- 注册 2011-4-14
- 行业 商业贸易
别拿你的身体当过滤器了!
如今许多人都谈“霾”色变,
但却对室内空气污染知之甚少。
据世界卫生组织发布的《室内空气污染与健康》报告显示,室内空气污染造成的总疾病超过室外空气污染造成的5倍。同时,由于人们每天平均大约有80%以上的时间在室内度过,因此室内空气质量对于人体健康的影响更为密切。
造成室内空气污染的推手无处不在,家家户户每天烹调产生的油烟就是其中之一,更不用说人人惧怕的“二手烟”。此外,室内遍布的真菌、尘螨,不少家用电器产生的电磁辐射,以及建筑材料、家居装饰、日常生活和办公用品释放的甲醛、苯等,都会造成可怕的室内空气污染,造成身体不适,甚至诱发神经系统、呼吸系统等疾病,严重的还可能引发肺癌。
长期待在如此室内的你,肺部充当了滤水器的“滤网”的作用,过滤着多样污染夹杂的空气,滤水器尚且只在工作时才运转,而你的肺部是24小时超负荷工作!

其实,你可以让净卫士硅藻泥帮你净化空气
净卫士硅藻泥作为不断创新升级新建材,净化空气原理与普通硅藻泥或活性炭类似,都是因为多孔的物理结构。但相比之下,净卫士硅藻泥有更胜一筹,主要是因为净卫士硅藻泥的净化过程分为2个步骤。
>>>>硅藻土物理吸收
含有很多细小的微孔,孔隙率达到90%,是木炭或活性炭的5000-6000倍,加上具有独特的分子筛及分子晶格结构,选择吸收功能非常强大,可以吸收室内甲醛、苯、VOC等有毒害物质,以及烟味、宠物体味等刺鼻难闻的异味。

>>>>艾米达酮化学分解
硅藻泥添加艾米达酮成分将这些有害物质加以分解,转化成无毒的水和二氧化碳等物质,能够切断这些污染物的化学键,使之分解,不会出现像其他硅藻泥“达到饱和状态”的情况,做到完全无害化处理。
物理吸收、化学分解,双管齐下令你的肺部不再受家居污染的摧残,在家享受真正深呼吸。
[ 本帖最后由 左岸浮华 于 16-7-15 13:54 编辑 ]
- 来自 江苏省
- 精华 0
- 注册 2011-4-14
- 行业 商业贸易
- 来自 江苏省
- 精华 0
- 注册 2011-4-14
- 行业 商业贸易
- 来自 江苏省
- 精华 0
- 注册 2011-4-14
- 行业 商业贸易
- 来自 江苏省
- 精华 0
- 注册 2011-4-14
- 行业 商业贸易
净卫士硅藻泥房带你体验不一样的夏天
夏天是什么呢?是睡不完的午觉,快要化掉的雪糕,像奶声奶气的猫咪突然长大,啊,还有年轻的姑娘在薄荷味汽水里明媚的笑着,像放在桌子上的玻璃杯折射出阳光耀眼的明亮。
▲ 在闲暇的午后,饮一杯奶茶或是啜一盏清茗,躺在松软的沙发中,呼吸着清新的空气,简单干净的墙面,轻而易举的便能带给你一天的好心情。
净卫士硅藻泥呼吸调湿的功能,在室内潮湿时,其微孔将空气中的水分吸入并储备;当室内空气中水分减少、湿度下降时再把吸入的水分释放出来,从而让室内充满凉爽之感。
另外,硅藻泥的主要成分是硅藻土,它的热传导率很低,所以在一定程度上可以阻隔室外的热量,让室内一直处于凉爽的环境氛围。
在舒适的硅藻泥房中,清新凉爽成为独有的体验。
这个夏天,在你的心里,又是怎样的一个味道?
[ 本帖最后由 左岸浮华 于 16-7-20 22:13 编辑 ]
- 来自 江苏省
- 精华 0
- 注册 2011-4-14
- 行业 商业贸易
















欢迎广大网友提前来探店





